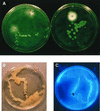

Bacteria in the leaf ecosystem with emphasis on Pseudomonas syringae-a pathogen, ice nucleus, and epiphyte
- PMID: 10974129
- PMCID: PMC99007
- DOI: 10.1128/MMBR.64.3.624-653.2000
Bacteria in the leaf ecosystem with emphasis on Pseudomonas syringae-a pathogen, ice nucleus, and epiphyte
Abstract
The extremely large number of leaves produced by terrestrial and aquatic plants provide habitats for colonization by a diversity of microorganisms. This review focuses on the bacterial component of leaf microbial communities, with emphasis on Pseudomonas syringae-a species that participates in leaf ecosystems as a pathogen, ice nucleus, and epiphyte. Among the diversity of bacteria that colonize leaves, none has received wider attention than P. syringae, as it gained notoriety for being the first recombinant organism (Ice(-) P. syringae) to be deliberately introduced into the environment. We focus on P. syringae to illustrate the attractiveness and somewhat unique opportunities provided by leaf ecosystems for addressing fundamental questions of microbial population dynamics and mechanisms of plant-bacterium interactions. Leaf ecosystems are dynamic and ephemeral. The physical environment surrounding phyllosphere microbes changes continuously with daily cycles in temperature, radiation, relative humidity, wind velocity, and leaf wetness. Slightly longer-term changes occur as weather systems pass. Seasonal climatic changes impose still a longer cycle. The physical and physiological characteristics of leaves change as they expand, mature, and senesce and as host phenology changes. Many of these factors influence the development of populations of P. syringae upon populations of leaves. P. syringae was first studied for its ability to cause disease on plants. However, disease causation is but one aspect of its life strategy. The bacterium can be found in association with healthy leaves, growing and surviving for many generations on the surfaces of leaves as an epiphyte. A number of genes and traits have been identified that contribute to the fitness of P. syringae in the phyllosphere. While still in their infancy, such research efforts demonstrate that the P. syringae-leaf ecosystem is a particularly attractive system with which to bridge the gap between what is known about the molecular biology of genes linked to pathogenicity and the ecology and epidemiology of associated diseases as they occur in natural settings, the field.
Figures

References
-
- Abe K, Watabe S, Emori Y, Watanabe M, Arai S. An ice nucleation active gene of Erwinia ananas: sequence similarity to those of Pseudomonas species and regions required for ice nucleation activity. FEBS Lett. 1989;258:297–300. - PubMed
-
- Ahmer B M M, van Reeuwijk J, Watson P R, Wallis T S, Heffron F. Salmonella SirA is a global regulator of genes mediating enteropathogenesis. Mol Microbiol. 1999;31:971–982. - PubMed
Publication types
MeSH terms
Substances
LinkOut - more resources
Full Text Sources
Other Literature Sources
Miscellaneous